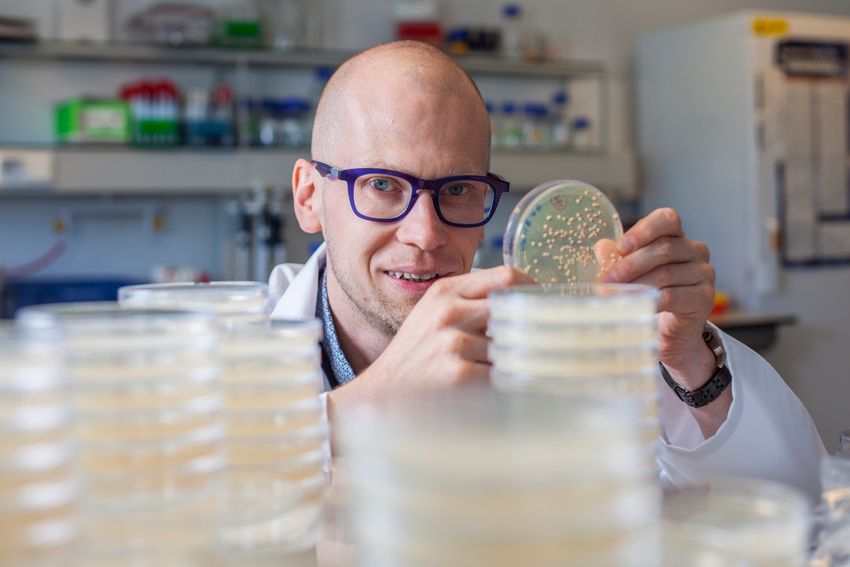
Kevin Verstrepen, wearing glasses, a patterned shirt, and a white lab coat, sits in his laboratory bench behind a stack of agar plates. He’s holding one up and pointing at it.

From the reliable pipette to the complex confocal microscope, laboratory tools enable scientists to make exciting discoveries that move science and health research forward. The editors at The Scientist asked researchers about their favorite laboratory instruments, and if they could be any one of them, which would they be. From cameras to spectrophotometers, these scientists could outfit an entire research lab from the technologies they’d like to become.
Flow Cytometers for Flexibility and Precision
Grace Bushnell, cancer biologist and engineer, University of Minnesota
I have to say a flow cytometer. It’s so flexible in terms of the different types of experiments that you can do and questions that you can ask. They can be a little bit finicky—at least the older flow cytometers required a lot of love to make sure that they worked properly, but they're getting better for sure. And I think the number of things that you can do now with spectral flow cytometry is so cool. The flow cytometer is basically my favorite instrument.
Kevin Verstrepen
Kevin Verstrepen, geneticist and microbiologist, Flemish Institute for Biotechnology and the Catholic University of Leuven
Two came to me spontaneously. For one, I would be a pipette because it's such a core piece of equipment in a molecular biology lab that everybody needs it. You’re not too special, but you're still very important. You need to be precise. The other one that came to mind would be a flow cytometer, just because that is on the other side of the spectrum. It's an expensive piece of equipment. It's highly technical. A lot of people rely on you, so I would like to be a piece of equipment that's highly useful to a lot of people.
Microscopes to See into Complex Worlds

Benjamin Baah Konadu
Benjamin Baah Konadu, neurobiology PhD student, Georgetown University
I think I'll be a microscope because microscopes really expand our view of what we think the world is. It gives us a different perspective of how small things contribute to larger things.
Frank Raven, neurobiologist, University of Michigan
I'm going to go for a microscope. Looking at neurons all day would be just so beautiful. Being able to visualize the tiny aspects of how our brain functions, that would be my favorite.
Shannon Tessier, molecular biologist and biochemist, Harvard Medical School & Massachusetts General Hospital
I would probably say a live imaging microscope. You could zoom me into the tissue as this little, tiny observer, and I could look around to see what's happening. Connecting the microscopic, even molecular changes, up to the macroscopic ones would be really helpful.

Fluence Photography
Isabella Batina, medical doctor, Ponce Clinical Research Site
If I could be a laboratory instrument, I would be a microscope. I’ve always been fascinated by how a microscope allows us to see beyond the surface—revealing details that are invisible to the naked eye but essential to understanding the whole picture. In many ways, that’s how I approach my work in HIV prevention research. I’m drawn to the small, often-overlooked factors that shape people’s access to care: language, culture, stigma, and trust. Like a microscope, I strive to bring those details into focus so they can inform more compassionate and effective interventions. I also love that microscopes symbolize curiosity and discovery—two qualities that keep me excited about research every day. Whether I’m learning from a participant’s story or analyzing study data, I aim to look closer, ask deeper questions, and see the world with clarity and empathy.

Sarvesh Kumar
Priya Bhardwaj, biomedical scientist, Washington University School of Medicine in St. Louis
I’d be a confocal microscope, the ultimate detective of the cell world. It doesn’t just look; it dives into the depths, peeling back layers of fluorescence to uncover secrets hidden in plain sight. That’s exactly how I approach science—curious, patient, and always chasing clarity in the chaos. I love how the confocal turns ordinary slides into cosmic landscapes—vibrant, mysterious, and full of stories waiting to be told. In my lab, I’ve spent countless hours watching bone and brain tissues glow under its lens, each image feeling like a tiny galaxy revealing how hormones and metabolism shape life.
If I were a confocal microscope, I’d be the one that never tires of zooming in just one more time, because you never know when the next breathtaking pattern will appear. Science, like a confocal image, is best appreciated one layer at a time with curiosity, color, and a bit of wonder.

Zahra Nawaz
Zahra Nawaz, immunologist, Emory University School of Medicine
If I could be a laboratory instrument, I would be a confocal microscope. I’ve always been a visual person, and during my PhD, using the confocal felt like peering into a hidden world where cells revealed their inner stories through light and color. It’s fascinating how this instrument captures intricate spatial details, turning invisible molecular interactions into vivid, three-dimensional images.
Being a confocal microscope would mean having the power to visualize complexity with clarity; to focus precisely, layer by layer, until the complete picture emerges. I love that blend of art and science, where data becomes something beautiful and informative at the same time. Just like a confocal, I’m drawn to seeing things from different depths and perspectives, uncovering fine details that others might overlook. It’s that curiosity and appreciation for visual discovery that makes the confocal my perfect scientific alter ego.
Electrophoresis Instruments to Reveal Nucleotide Secrets

Francesca Telford
Max Telford, zoologist, University College London
I'd be a gel electrophoresis machine because we always get a result from them, even if it’s a negative one. It's one of those things that in 30 minutes you get some sort of result. It's not one of those decades-long experiments. It's immediate gratification but with a little bit of anticipation thrown in.
Matthew Girgenti, neuroscientist and molecular biologist, Yale University
My first inclination is to be a TapeStation. This way I can always tell my lab whether their DNA and RNA is of high or low quality.
Spectrophotometers to Shed Light on Science

Coptis
Deepika Godugu, pharmaceutical scientist, St. Johns University
If I could be a laboratory instrument, I would be a spectrophotometer. The spectrophotometer reveals hidden details by measuring light absorption, helping scientists uncover what’s invisible to the naked eye. It is all about clarity and insight.
Anurag Roy, experimental materials chemist, University of Exeter
I’d probably be a spectrophotometer. It’s all about analyzing and understanding materials by how they interact with light—kind of like how I try to uncover the hidden properties of materials in my research. Plus, it’s versatile and essential in many experiments, quietly providing important data behind the scenes. I like the idea of being that reliable tool that helps make sense of complex information.
Computers and Cameras Remember and See Easily

Shambhavi Garde
Divya Tej Sowpati, computational genomics researcher, Center for Cellular and Molecular Biology
I will be a computer because then I can process a lot of things much faster and not have to worry about my dwindling memory issues.
Hasan Bazzazzadeh, architectural engineering scientist, Swiss Federal Laboratories for Materials Science and Technology

Hassan Bazazzadeh
I would be a high-precision thermal camera. It is an instrument that can “see” what the human eye cannot, revealing hidden patterns in temperature, energy loss, and comfort levels in buildings and cities. Much like my own approach to research, a thermal camera works quietly in the background, collecting detailed data that can be transformed into actionable insights. It bridges the gap between raw measurement and meaningful understanding, helping others make informed decisions. I like the idea of being a tool that brings clarity to complex situations, capturing both the big picture and the fine details. A thermal camera’s ability to adapt to different environments and applications also reflects how I enjoy working across diverse challenges, from simulation to real-world measurements. Plus, there is something fascinating about being able to uncover invisible truths, turning them into knowledge that can drive change.
Responses have been edited for length and clarity.













